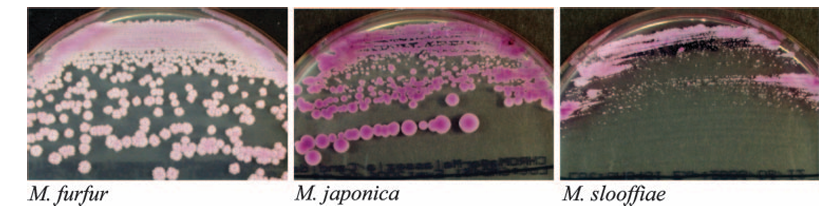
image 109 Malassezia colonies on CHROM agar

Malassezia spp. (previously called pityrosporum) are unipolar, lipophilic commensal yeasts.
Recent studies indicate approximately 18 species present in this genus.
Malassezia spp., under some conditions, are known to cause skin disease ranging from superficial mycoses like pityriasis versicolor to severe inflammatory disorders like atopic dermatitis.

- There has been an increasing frequency of reports linking Malassezia spp. to cause systemic infection among immunocompromised and premature neonates.
- Malassezia spp. belong to the Basidiomycota phylum, Ustilaginomycotina subphylum, Malasseziomycetes class, Malasseziales order, and Malasseziaceae family.
- They lack genes to encode for fatty acid synthase, hence have nutritive dependence on the exogenous lipid, such as that present in the seborrheic area of the human skin.
Morphology of Malassezia spp.
- The morphology is usually described as “spaghetti and meatballs”.
- Malassezia spp. can exist in both yeast and mold form, but aren’t considered the classic dimorphic fungi.
- The yeast is oval or bottle-shaped and shows unipolar budding. The mold form has short, curved, septate hyphae (pseudohyphae).
Habitat of Malassezia spp.
- They are part of the normal human microbiota. They are lipid dependent (except M. pachydermitis) and mostly abundant in seborrheic areas of the body, like the scalp, trunk, face, and upper back.
- Malassezia spp. particularly of species M. restricta and M. globose, are considered to be the most abundant fungal microbiota in human skin.
- Due to a small genome size (4,285 genes), they acclimatized in a limited localized niche.

Source: DOI:10.1016/S1578-2190(08)70364-0
Lifecycle of Malassezia spp.
- Malassezia spp. reproduced by asexual unipolar budding.
- Some conditions, like high sebum production, high humidity, and high temperature, trigger morphogenesis into yeast form.
Virulence factor of Malassezia spp.
- Extracellular lipase: To break down sebum lipids, lipase enzymes (lipase and phospholipase) are secreted by Malassezia spp. The unsaturated fatty acid byproduct merges with the fungal cell membrane, increasing the resistance, osmoresistance, and enhancing the mechanical properties of its hyphae form.
- Indoles: In the presence of a nitrogen source like tryptophan, Malassezia spp. converts the product into indole alkaloids (e.g., indirubin, malassezin, and indolo [3,2-b] carbazole). These indole alkaloids act as ligands and bind to aryl hydrocarbon receptor (AhR) and modulate epidermal cell function.
- Reactive Oxygen Species: Malassezia spp. are known to produce reactive oxygen species, which are mediated by lipid peroxidase. Some species that are known to produce ROS include: M. furfur, M. pachydermitis, M. globose, M. sympodialis, M. obtuse, and M. slooffiae.
- ROS causes oxidation of major proteins and enzymes and exerts cytotoxic effects on the host cell.
- Melanin production: Malassezia spp. in the presence of L-3,4-dihydroxyphenylalanine (L-DOPA) can produce melanin, which helps them to minimize the effect of nitric oxide production inside the macrophage.
- Lipoxygenase: The breakdown of sebum lipid and the elevated level of unsaturated fatty acid byproduct increase the expression of lipoxygenase.
- Lipoxygenase catalyzes the production of H2O2 from unsaturated fatty acids, which can lead to oxidative stress in the host cell, stratum corneum destruction, and can also be carcinogenic.
- Azelaic acid: It is produced as a byproduct from the oxidation of unsaturated fatty acids by lipoxygenase. It inhibits the tyrosinase and leads to depigmentation (or hypopigmentation) in pityriasis versicolor.
- It also inhibits the fungicidal effect of reactive oxygen produced by the host cell.
- Cell surface hydrophobicity (CSH): Malassezia spp. express CSH (due to high lipid content in their cell wall), with the highest being in M. furfur. CSH allows the cell to adhere to the host tissue. In keratinocytes, it also triggers the production of pro-inflammatory cytokines.
- Hyphae formation: It is one of the essential virulence factors because of its invasive nature in the epidermis. Excess sebum production triggers this morphogenesis. Hyphae (sometimes pseudohyphae) morphogenesis is seen in pityriasis versicolor.
Host response to Malassezia spp.
When the yeast is exposed on the skin (stratum corneum), it interacts with keratinocytes, dendritic cells, and macrophages.
Through this exposure, two types of interaction take place:
Direct interaction
This occurs via the receptors (Pattern-recognition receptors) present on macrophages, epidermal Langerhans cells, dendritic cells, and keratinocytes.
- There is variability in receptor expression in hematopoietic cells (myeloid cells) and non-hematopoietic cells (keratinocytes).
- PRRs of family Syk-coupled C-type Lectin Receptor (CLRs) (are present mainly in hematopoietic cells) that recognize the carbohydrates and glycoproteins present on the cell wall of Malassezia spp.
- C-type Lectin Receptors consist of Dectin-1, Dectin-2, Mincle, and Langerin. The carbohydrate recognition is calcium-dependent; this receptor is referred to as C-type.
- Dectin-1 recognizes β-glucan receptors and has been known to trigger activation of the NLRP3 inflammasome.
- Dectin-2 and Mincle are FcRγ-associated receptors. Dectin-2 recognizes α-1,2-linked mannose on the fungal cell wall, while Mincle recognizes the glycolipid.
- Langerin also recognizes and binds to mannose and β-glucan in the cell wall.
- Another distinct family of PRRs, i.e., Toll-like Receptors (TLRs) (particularly TLR2) in keratinocytes, also participates in fungal recognition. It can trigger proinflammatory responses, like chemokines and antimicrobial peptides.
- Based on the situation, the receptors can either induce an inflammatory response or an inhibitory response.
Indirect interaction
When the yeast metabolizes the exogenous lipid, it excretes byproducts, which can promote inflammatory response and contribute to pathogenesis or can downregulate the mediators of inflammation (which happens in the case of commensal interaction).
- Disintegration of exogenous sebum by lipase and phospholipase enzymes secreted by Malassezia spp. result in unsaturated free fatty acids byproducts like oleic acid and arachidonic acid.
- Arachidonic acids release proinflammatory eicosanoids that damage and degrade the stratum corneum, resulting in abnormal keratinization of skin.
- Oleic acid contributes to skin damage by desquamation of the keratinocytes.
- Indole alkaloids secreted by Malassezia spp. binds the AhR receptor and modulates the response of that particular cell (triggers apoptosis of melanocytes).
- M. furfur is known to implement this pathway to trigger inflammation or anti-inflammation and is also responsible for causing skin carcinoma.

Source: doi: 10.3389/fimmu.2017.01614
Disease Caused by Malassezia spp.
Malassezia spp. are mainly associated with causing skin diseases.
Pityriasis versicolor
Clinical feature: Characterized as a small, patchy, scaly hypopigmented (in darker skin) and hyperpigmented (in lighter skin) appearance with no visible inflammatory response.
- Indole alkaloids production has been attributed in inhibiting the inflammatory response.
- The hyphal form is mainly seen in this condition.
- M. furfur, M. globosa & M. sympodialis are most concurrently isolated.
Seborrheic dermatitis
Clinical feature: Characterized as itchy, flaky, scaly (white or yellow), inflammatory, chronic eczema.
- M. globosa & M. retricta are mostly isolated species in this infection.
- It is frequently localized in sebum-rich areas like the scalp and face.
- Unsaturated fatty acid byproducts, like oleic acid and arachidonic acid, after lysis of sebum lipid by lipases, result in abnormal keratinocytes and proinflammatory response.
Atopic dermatitis
Clinical feature: Characterized as chronic, itchy, dry, discolored patches (red, purple-grayish). The stratum corneum is dehydrated due to transepidermal water loss, and there is also increased pH in the skin.
- The increased pH of skin triggers allergen production by Malassezia spp., which are sensitized by atopic individuals.
- The allergens are recognized by TLR2 (in keratinocytes and dendritic cells), which triggers the release of pro-inflammatory cytokines like IL-1, IL-4, and IL-13.
- The allergens prompt the release of Malassezia-specific IgE, which further perpetuates the inflammation.
Malassezia folliculitis
Clinical features: Characterized by itchy erythematous pustules on the pilosebaceous unit, mainly on the trunk but also occasionally on the face and neck.
Cultural characteristics of Malassezia spp.
- Sabouraud’s Dextrose Agar: The media isintegrated with cycloheximide and olive oil (for lipid). The colonies appear small, smooth, and pale white to cream-colored.
- CHROMagar Malassezia medium: M. furfur gives large, pale pink, wrinkled colonies, M. japonica gives large, purple, smooth colonies, while M. slooffiae shows small, pale pink, smooth colonies.
- Modified Dixon’s agar: Colonies appear cream-yellowish in color, can be either smooth or slightly wrinkled with an entire or irregular margin.
Source: doi:10.1128/JCM.01243-07
Diagnosis of Malassezia spp.
- Pityriasis versicolor: The lesion exhibits yellow-orange fluorescence under Wood’s light (UV lamp). Direct microscopy in a 10-15% KOH preparation with 20% blue-black ink added to the skin scrap shows bottle-shaped to oval yeast cells along with curved hyphae.
- Seborrheic dermatitis: Diagnosis is mostly based on clinical features.
- Atopic dermatitis: Skin prick test and blood test to detect Malassezia-specific IgE through the standardized kit ImmunoCAP m70, Phadia.
- Malassezia folliculitis: Gram staining using KOH of pustules, which shows unipolar budding and follicular dilatation and a high number of conidia but no hyphae, is mainly observed in histopathological tests.
Treatment of Malassezia spp. Infections
- Pityriasis versicolor: Application of topical antifungals like 2% ketoconazole or 2% selenium sulphide cream, or shampoo.
- Sebaceous dermatitis: Application of topical azole antifungals like ketoconazole and ciclopirox.
- Atopic dermatitis: Topical steroids and calcineurin help improve defective stratum corneum. Then, antifungal agents, mainly azoles (ketoconazole), are used to impose anti-inflammatory effects along with antifungal action.
- Malassezia folliculitis: Application of topical antifungals like azoles, selenium sulfide, and 50% propylene glycol.
Conclusion
Malassezia spp. are widely known to cause pityriasis versicolor, a superficial mycosis. The yeast has also been implicated in causing other severe form of epidermal diseases, which stems from its diversified virulence factors. The correlation and causation of this yeast with other serious epidermal disorders should be comprehended more intricately.
References
- Cheesbrough, M. (2006). District Laboratory Practice in Tropical Countries (2nd edition). Cambridge University Press.
- Glatz, M., Bosshard, P.P., Hoetzenecker, W. & Schmid-Grendelmeier, P. (2015). The Role of Malassezia spp. in Atopic Dermatitis. J. Clin. Med., 4(6), 1217-1228. doi: 10.3390/jcm4061217
- Greenwood, D., Barer, M., Slack, R. & Irving, W. (2012). Medical microbiology (18th edition). Churchill Livingstone Elsevier.
- Kaneko, T., Makimura, K., Abe, M., Shiota, R., Nakamura, Y., Kano, R., Hasegawa, A., Sugita, T., Shibuya, S., Watanabe, S., Yamaguchi, H., Abe, S. & Okamura, N. (2007). Revised Culture-Based Sytem for Identification of Malassezia Spp. J. Clinc. Micro., 45(11), 3737-3742. doi:10.1128/JCM.01243-07
- Kurniadi, I., Wijaya, W.H. & Timotius, K.H. (2022). Malassezia virulence factors and therir role in dermatological disorder. Acta Dermatovenerol APA, 31(2), 65-70. doi: 10.15570/actaapa.2022.8
- Łabedz, N., Navarrete-Dechent, C., Kubisiak-Rzepczyk, H., Bowszync-Dmochowksa, M., Pogorzelska-Antkowiak, A. and Pietkiewicz, P. (2023) Pityriasis versicolor- A narrative review on the diagnosis and management. Life, 13, 2097. doi: 10.3390/life13102097
- Saunte, D.M.L., Gaitanis, G. & Hay, R.J. (2020). Malassezia-Associated Skin Diseases, the Use of Diagnostic and Treatment. Front Cell Infect. Microbiol., 10, 112. doi:10.3389/fcimb.2020.00112
- Sparber, F. & LeibundGut-Landmann, S. (2017). Host Responses to Malassezia spp. in the Mammalian Skin. Front. Immunol., 8, 1614. doi: 10.3389/fimmu.2017.01614
- Tille, P.M. (2014). Bailey & Scott’s Diagnostic Microbiology (13th edition, pp. 705-757). Elsevier Mosby.